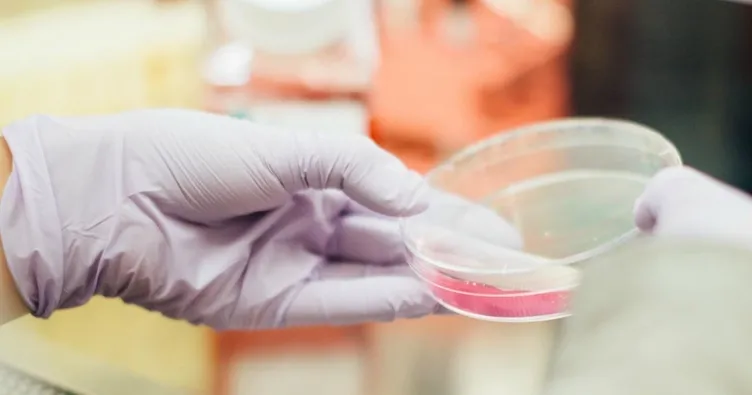

Ankara'da "Lenfoma Farkındalık Günü" nedeniyle hastaların ve hekimlerin bir araya geldiği bir toplantı düzenlendi. Ankara Üniversitesi Tıp Fakültesi Hematoloji Bilim Dalı Öğretim Üyesi Prof. Dr. Muhit Özcan, lenfomada zamanında tanının ve doğru tedavinin çok önemli olduğunu belirterek, "Bu nedenle burada tedavi olmuş hastalar aile yakınları ve tedavi eden uzmanlar bir araya geliyorlar, deneyimlerini paylaşıyorlar, gelişmeleri birlikte algılayıp diğerine neler yapmaları gerektiğini değerlendiriyorlar. Lenfoma tedavisi bitse dahi lenfomayla mücadele ömür boyu sürmesi gerekiyor. Sürekli de yenilikler olduğu için hastaların tecrübelerini birbiriyle paylaşmaları büyük bir değer taşıyor" diye konuştu.
LENFOMADA YAŞ BİR RİSK FAKTÖRÜ
Kanserlerin en temel iki sebebinin sigara ve aşırı kilo olduğunu vurgulayan Prof. Dr. Özcan, "Bunun dışında birçok irili ufaklı sebep sayılabilir ancak hiçbir risk faktörü olmayan insanlarda da kanser görülebilir. Lenfoma, 60 yaşından sonra giderek artan bir hastalık. Dolayısıyla bir numaralı risk faktörü yaşlılıktır" şeklinde konuştu. Lenfomanın kendisini gizleyen bir hastalık olmadığını söyleyen Özcan, lenfomanın boyunda, kasıkta veya koltuk altında beliren ağrısız yumrularla kendini gösterdiğini ifade etti. Öte yandan Özcan, aşırı gece terlemesi, akşamları 39 ile 40 derecede sebepsiz ateş, kilo kaybı ve sebebi belirlenemeyen kaşıntıların da belirtiler arasında olabildiğini kaydetti.
TANIYI PATALOGLAR KOYAR
Lenfoma tanısının pataloglar tarafından konulduğunun altını çizen Özcan, "Bazı lenfomalar, 10 yılı aşkın sessiz kalabiliyor ve hiç ilaç gerektirmeyebiliyor. Teknolojidekive ilaç sanayideki gelişmeler, bilgisayarın sisteme dahil olması, moleküler biyoloji alanında gelişmeler son 20 yılda artık lenfomada yeni milenyum başka bir isimle başladı. Çok yakın bir zamanda kemoterapi çağı tamamen kapanmış olacak"